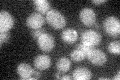
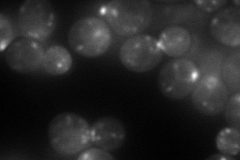
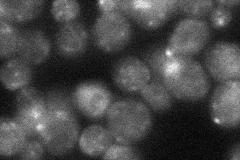
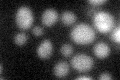
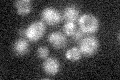

View description
GTPase of the Ypt/Rab family, very similar to Ypt31p; involved in the exocytic pathway; mediates intra-Golgi traffic or the budding of post-Golgi vesicles from the trans-Golgi
Localization:
Intensity:
Fold change:
Significance:
-
C’ GFP library in SD
below threshold16.02 -
N' NOP1pr-GFP in SD
punctate,bud neck98.218 -
N' TEF2pr-mCherry in SD

ER,punctate,bud167.283 -
N' NATIVEpr-GFP in SD
punctate,bud neck26.6618 -
N' TEF2pr-VC and Cyto-VN in SD

punctate,bud neck48.6478 -
C’ GFP library in SD+DTT
cytosol15.550.97No -
C’ GFP library in SD+H2O2
cytosol14.540.9No -
C’ GFP library in Starvation Media

cytosol15.030.93No -
C’ GFP library on the background of Pup2-DaMP

below threshold -
C’ GFP library on the background of CCT mutant

below threshold14.96580.933882No
